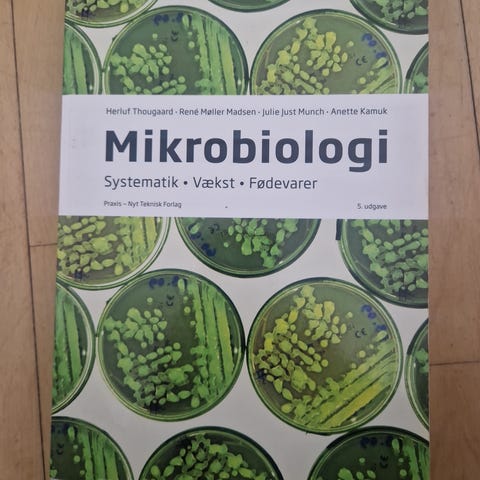

Billedgalleri
Munksgaard Mikrobiologi – hånden på hjertet lærebog biologi
Til salg
Fragt fra 29,99 kr. + Tryg betaling 11 kr.
Tryg handel med Fiks færdig
Fiks færdig er DBA's nye betalings- og fragttjeneste. Efter levering har du 24 timer til at kontrollere varen, før pengene udbetales til sælgeren.
Varebeskrivelse
Stand: Brugt - men i god stand
Emne: Biologi
Munksgaard "Mikrobiologi – hånden på hjertet" lærebog i biologi. Bogen gennemgår grundlæggende mikrobiologi med fokus på opbygning, funktion og betydning af mikroorganismer. Indholdet dækker blandt andet bakterier, virus, svampe og parasitter samt deres rolle i sygdom og sundhed. Velegnet som fagbog til naturvidenskabelige og sundhedsfaglige uddannelser, hvor der arbejdes med anatomi, fysiologi, biologi og beslægtede emner. Hardback-udgave på dansk.
E-NØGLE BRUGT
Brugerprofil

Du skal være logget ind for at se brugerprofiler og sende beskeder.
Log indAnnoncens metadata
Sidst redigeret: 4.4.2026 kl. 06:53 ・ Annonce-ID: 20184035